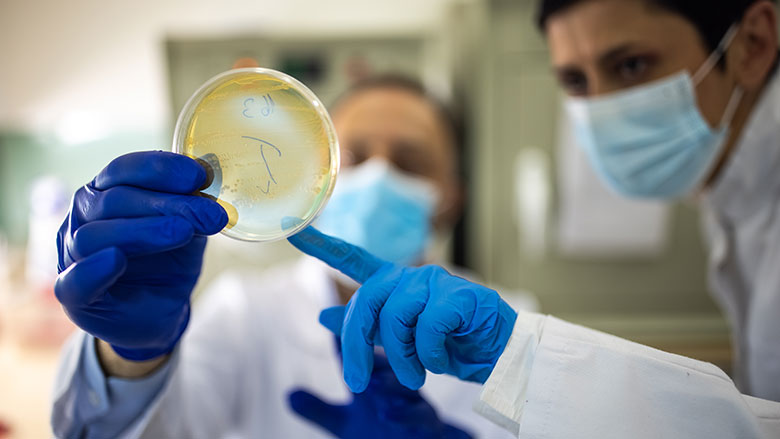

EU Reports High AMR in Salmonella, Campylobacter
Credit: miodrag ignjatovic/E+ via Getty Images
The European Center for Disease Prevention and Control (ECDC) and the European Food Safety Authority (EFSA) have released a report that shows antimicrobial resistance (AMR) in Salmonella and Campylobacter is high. ECDC and EFSA annually collect and analyze data on AMR in animals and food throughout the EU; the report, which covers 2019–2020, focuses specifically on poultry, pigs under one year of age, and calves under one year of age. The report includes data regarding Salmonella, Campylobacter, indicator Escherichia coli isolates, and presumptive ESBL‐/AmpC‐/carbapenemase‐producing E. coli isolates. This report does not include data from the United Kingdom due to its exit from the EU.
Antimicrobials, such as antibiotics, are drugs used to treat or prevent illnesses caused by microorganisms. AMR in bacteria is a concern because pathogens with high levels of AMR cause illnesses that are more difficult to treat.
The reported findings and trends include:
- AMR in Campylobacter and some strains of Salmonella remains high
- Campylobacteriosis was the most reported cause of foodborne illness in the EU in 2020
- Campylobacter in humans and poultry show very high resistance to ciprofloxacin, a commonly-used antimicrobial in humans
- Salmonella, Campylobacter, and E. coli show low levels of combined resistance (resistance to two different antimicrobials) to crucial antimicrobials
- Great progress has been made in reducing AMR in food-producing animals in several EU member states
- Resistance to carbapenem antimicrobials is very rare, with less than five resistant isolates identified; resistance to carbapenem antimicrobials is of concern because they are reserved for the treatment of severe, high-risk infections involving multidrug-resistant pathogens in humans.
The report recommends prudence in the use of antimicrobials across all sectors, including agriculture, and further investigation of carbapenem-resistant isolates in livestock.
Looking for a reprint of this article?
From high-res PDFs to custom plaques, order your copy today!







